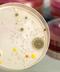

Autism Associated with Superior Visual Skills in Infancy
 For the first time, a study has shown that babies, diagnosed with emerging autism at 15 months to two years old, can exhibit enhanced visual searching abilities as early as nine months old.
For the first time, a study has shown that babies, diagnosed with emerging autism at 15 months to two years old, can exhibit enhanced visual searching abilities as early as nine months old.
The finding, reported by a Birkbeck College London/Kings College London team in Current Biology, indicates emerging autism may be linked to unusual perceptual abilities.
“Although visual search enhancements have been noted for toddlers with autism, this is the first study to examine visual search in infants and toddlers at risk for an autism spectrum disorder (ASD), and to note that visual search enhancements can predict not only ASD symptoms, but also the severity of symptoms,” Syracuse University assistant professor of psychology Natalie Russo, Ph.D., told Bioscience Technology. Russo was uninvolved in the study.
“This is a very important first step in demonstrating the primacy of enhancements in visual search in ASD, and their presence very early on in development, before the full symptoms of autism are evident,” Russo said.
Details
Some people with autism can demonstrate an astonishing gift for detail. The character in the movie “Rain Man,” based on a real person, could total in his mind hundreds of toothpicks immediately after they spilled. The autistic artist Stephen Wiltshire draws entire cityscapes from memory.
Teodora Gliga, Ph.D., a psychologist with Babylab, which is part of the University of London’s Centre for Brain and Cognitive Development at Birkbeck, was lead author on the study. She had earlier noticed that most studies zero in on autism patients’ language and social impairments, not their non-social motor and perceptual abilities.
Read More: Autism Linked to Genetic Mutation – and Researchers Say They Can Undo it
So Gliga first sought out infants known to be at higher risk of autism based on the diagnosis of an older sibling. Some 20 percent of younger siblings also have autism. Some 30 percent of younger siblings exhibit heightened levels of autism symptoms.
Infants tend to stare at anything that appears unusual to them; for example, one letter that is different within a group of identical letters. To analyze perceptual skill, Gliga’s team used an eye tracker to record infants' stares as they were given letters on a screen to view. The team also analyzed younger siblings for autism signs at 9 months, 15 months, and two years via standard screening methods.
The study showed that infants with enhanced visual searching ability at nine months old also had more emergent autism symptoms at 15 months, and at two years. The finding suggests that the unusual perceptual ability of those infants is linked to emerging autism.
A fir st
st
“This is the first time that superior abilities, measured in infancy, were shown to relate to emerging autism symptoms,” Gliga told Bioscience Technology. “It was definitely surprising to see this relationship so early in development, at nine months. This suggests perception might play a causal role in the onset of core autism symptoms: the social interaction difficulties and delayed language, among them.”
That enhanced visual ability, however, did disappear later in the development of infants who turned out to have autism. “That this relationship disappears at 15 months has many implications,” Gliga said. “First, it makes it even more clear that we need to investigate very early development. Had we only seen children one year old and older, we would have missed it.”
Second, Gliga said, the loss of the enhanced visual perception at 15 months suggests there may be “critical windows in development, when perception is particularly needed for the development of other skills. For example, perception may be needed for learning about objects and their names” earlier on.
Finally, Gliga told Bioscience Technology, her study indicates that the infantile superior perception she unearthed, and the more commonly noticed “later superior skills of individuals with autism…may not be related.”
Overall the new work, Gliga believes, may help engineer a shift in autism work from the search for social autism-related problems, to the search for non-social autism-related problems, or non-social markers of autism.
“I think this shift is already happening and may now accelerate,” Gliga said. “Other groups are looking at motor development, and yet others at whole brain anatomy. One paper suggests that parents’ concerns about sensory and motor problems are earlier predictors of later autism than their concerns about social skills, or sleep/diet.”
Gliga thinks it is possible that, in general, qualities that enhance brain function—that do not degrade it—may be better markers to look for, as they may be more specific to autism.
“That is what we hope,” she concluded to Bioscience Technology. “At Birkbeck we are also following up a cohort of infants at risk for ADHD (attention deficit hyperactivity disorder). This will allow us to test the specificity of this marker. We also need to understand how exactly perception relates to core symptoms. Although we talk about ‘superior’ abilities, it is clear that they are not overall beneficial, as they may also interfere with typical learning and development.”

_itok-koBXLkpz.jpg)

